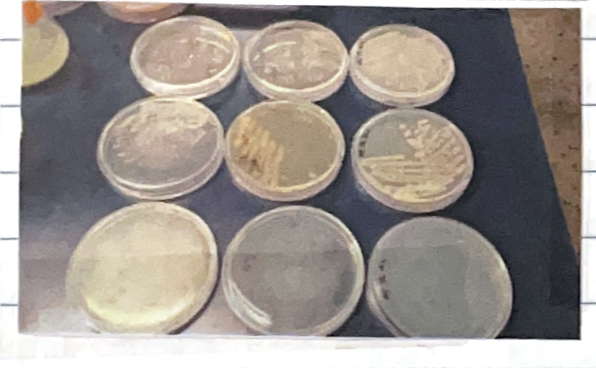
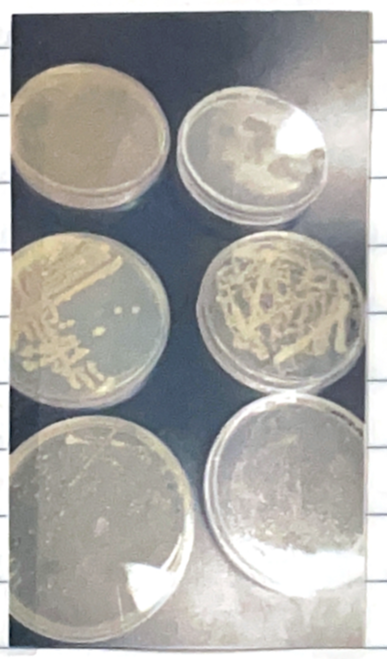

1. 실험 제목 : 미생물의 성장에 영향을 미치는 환경적 요인 - 온도, pH에 대한 영향
2. 실험 일시 :
3. 실험 목적 :
미생물의 성장과 생존은 물리적, 환경적 요인에 의해 상당한 영향을 받는다.
미생물의 성장에 영향을 주는 요인으로는 온도, 수소 이온의 농도 (pH), 삼투압, 자외선 등이 있으며 이러한 조건들은 미생물의 성장에 크게 영향을 미친다. Bacteria 생장에 요구되는 최적 온도, 최적 pH에 대해 알아본다.
4. 실험 원리 :
1) Temperature
미생물의 성장을 허용하는 온도의 범위는 균종에 따라 다르다.
*Cardinal temperature point
-Minimum growth temp : 성장이 일어날 수 있는 가장 낮은 온도. 이 온도의 밑으로는 효소의 활성과 세포 대사가 억제됨.
-Maximum growth temp : 성장과 대사가 일어날 수 있는 가장 높은 온도. 이 온도 이상에서는 성장이 중단되고, 효소가 파괴되고, 세포가 사멸함.
-Optimum growth temp : 최고 속도의 효소 반응. reproduction의 비율이 가장 빠름
*Classification of three major groups depending on temp
-Psychrophiles : -5 ~ 20'c (0~5'c)
-Mesophile : 20~45'c
-20~30'c : plant saprophytes
-35~40'c : in the bodies of warm - blooded hosts
-Thermophiles : 35'c and above
-Faculatative thermophiles : 37'c (opt temp : 45~60'c)
-Obligate thermophiles : 50'c (opt temp : 60'c ↑)
2) pH
균의 종류에 따라 성장이 가능한 pH범위와 최적 pH 값이 다르다. 지연 환경은 보통 pH 5~9 범위이므로, 보통 bacteria는 pH4~9에서 자라고 pH 6.5 ~ 7.5 사이가 optimum pH이다. 그러나 bacteria는 그들만의 specific 한 pH가 있으며 어떤 것은 넓거나 좁은 pH 범위를 가진다. pH 3~5에서 잘 자라는 호산성균 (acidophile)과 pH10 이상에서 자라는 호염기성균 (alkaliphile)도 있다. 대개 세균은 중성이나 약알칼리에서 잘 증식하는데 비해 효모나 곰팡이는 약산성 배지에서 잘 자란다. 미생물은 증식하면서 자기가 처한 환경의 pH가 균의 성장에 적합한지 잘 살펴봐야 한다.
ex) enteric bac(digestive system)
bacterial blood parasite : narrow range (pH 7.3에서 적당)
*Buffer : 미생물의 생장에 따른 pH의 급격한 변화를 막아줌
-보통 사용되는 buffering system
: addition of K2HPO4 ( a salt of a week base) and KH2PO4 ( a salt of a week acid)
-natural buffer : amino acids, peptone, protein 등
ex) amino acids
5. 실험 재료 :
실험 대상 미생물 (Escherichia coli) LB agar (4'c, 30'c, 60'c), LB broth (pH 4, 7, 10), cold-chamber, Incubator, pH meter, 백금이, 알코올램프
6. 실험 방법 :
1) 화염 멸균한 백금이를 오염되지 않도록 주의하면서 냉각시킨 후 1 colony 만을 취한다.
2) Broth는 백금이를 flask 목에 닿지 않도록 주의하면서 준비된 broth에 담가 천천히 휘저어준다.
3) Agar는 백금이를 단판 평판법을 이용해 접종한다.
4) Broth는 30'c, Agar는 각각 4'c, 30'c, 60'c에서 배양한다.
5) 다음날 결과를 확인한다.
7. 실험 결과 :
액체 배지에 pH3, pH7, pH10 환경에 대장균을 각각 접정하였고 고체 배지를 4'c, 30'c, 60'c에서 배양하였다.
그 결과 대장균은 pH7, 30'c에서 잘 자란 것으로 보인다.

8. 고찰 :
온도가 미생물 증식에 미치는 영향

최저 성장온도에서는 온도가 내려감으로 인해 세포막이 경직되므로 세포 내로의 물질 전달이 불가능해져서 생육이 힘들며,
최적 성장온도에서는 미생물의 성장속도가 가장 빠르고,
최고 온도 이상이 되면 단백질 손상으로 인해 효소의 변성이 일어나 세포의 성장에 필수적인 세포 반응을 촉매하지 못하게 되며, 세포막 중 단백질 성분이 손상되어 정상적인 세포막의 기능을 하지 못하게 되며 파괴된다.
최적 생장 온도에 따라 저온균, 중온균, 고온균 초고온균으로 나뉘는데,
저온균 (psychrophile)은 낮은 온도에서 최적의 생장온도를 보여주는 그룹이다.
중온균 (mesophile)은 중간온도에서 최적의 생장온도를 보이며 대부분의 미생물이 중온균이다.
고온균 (thermophile)은 높은 온도에서 최적의 생장온도를 보여준다.
초고온균 (Hyperthermophile)은 고온균보다 더 높은 온도에서 최적의 생장온도를 보인다.
내냉성 미생물 (phychrotoferant)은 0'c 이하에서도 자랄 수 있지만 최적 온도는 20~40'c인 생물이다. 이들은 변형된 세포막과 높은 불포화 지방산을 함유하고 있어 수송 과정도 낮은 온도에서 최적을 보여줘 분자 수준으로 적응한 존재들이다. 고온균은 최적 생장 온도가 45~80'c, 초고온균은 최적 생장온도가 80'c 이상인 개체들이다.
진핵 생물보다 원핵 생물이 더 높은 온도에서 살 수 있으며 광영양보다 비광영양 생물이 더 높은 온도에서 생존이 가능하다.
고세균이 가장 높은 온도에서 살 수 있으며 분자적 적응으로 효소와 단백질이 안정성을 제공한다.
pH는 단백질의 변성 금속 이온의 이용성, 세포막의 투과성 등의 변화를 가져와 미생물의 생육에 큰 영향을 미친다. 미생물들은 각기 증식이 가능한 pH 범위와 최적 pH가 있는데 대부분 미생물의 생육 최적 pH는 5.5~8이다. 일반적으로 세균은 중성 부근에서 잘 자라며 진균은 세균보다 내산성이 강하여 pH 4~6 정도에서 잘 증식한다. 호산성 (acidophile)은 pH 5.5 이하인 것, 호중성 (neutrophile)은 pH5.5 ~ 8.0, 호염기성 (alkalophile)은 pH8.5 이상에서 잘 자라는 것을 말한다.
9. 참고문헌
(생략)
'실험노트 > 일반미생물학 실험' 카테고리의 다른 글
| [실험노트] 일반미생물학 실험 8. 미생물의 번식 측정 O.D 측정 (0) | 2023.05.01 |
|---|---|
| [실험노트] 일반미생물학 실험 7. 세균의 측정 (pour plate method) (0) | 2023.04.30 |
| [실험노트] 일반미생물학 실험 6. 현미경을 이용한 미생물의 관찰 (0) | 2023.04.30 |
| [실험노트] 일반미생물학 실험 5. 현미경을 이용한 미생물의 관찰 (0) | 2023.04.14 |
| [실험노트] 일반미생물학 실험 4. 식품 등의 재료로부터 미생물의 순수 분리 (0) | 2022.08.31 |




댓글